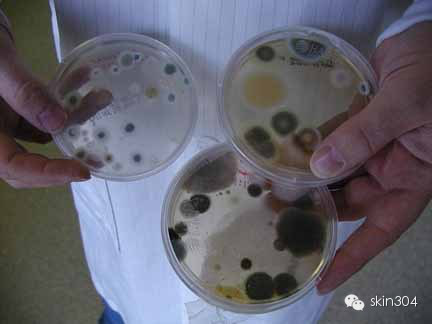

临床真菌学释疑
来源:优米app下载ios皮肤科 最后更新时间:2018年1月26日

真菌:“着色”、“暗色”与“透明”
这里涉及三个概念问题:“着色”在此指着色芽生菌病(chromoblastomvcosis),是由一组暗色真菌引起的皮肤及皮下组织的慢性、局限性、肉芽肿性、感染性疾病,该病的特征是在组织内形成暗色、厚壁、球形、分隔的硬壳小体(muriform bodies)。
“暗色”在此则是专指暗色丝孢霉病(phaeohyphomycosis),是指由一大组暗色真菌所引起的浅表、皮肤、皮下和系统的感染性疾病.该病的特点是在寄生组织内形成暗色的菌丝和/或孢子,其临床表现轻重不一,严重时可危及生命。着色芽生菌病和暗色丝孢霉病可以合称为着色真菌病(chromomycosis)。暗色真菌是一类菌丝和/或孢子的壁具有黑色素样颜色的真菌,细胞多呈淡褐至黑褐色,菌落色调呈黑色或褐色,绒毛样或酵母样。绝大多数为土壤的腐生菌。
“透明”在此特指透明丝孢霉病(hyalohyphomycosis),定义为曲霉以外的无色(透明)真菌引起的皮肤、皮下和深部组织感染,特征性表现是在组织中形成有隔菌丝相,但细胞壁中基本无色素(透明)。以上提及的三大类真菌感染在临床既不常见也非罕见.近年还有不断增多的趋势。诊断的金标准为组织病理显示有真菌成分存在和/或无菌取材真菌培养阳性,最后诊断通常要求注明“某菌所致某部位的某病(感染)”,如“新月弯孢霉所致下肢皮肤暗色丝孢霉病”。
真菌:共生、寄居、污染和感染?
几乎所有病原真菌均广泛分布于人类生活的环境中,如空气、水、林木花草、地面墙壁、家庭和办公用品、动物体表等等,因此,人类体表和腔口等部位能分离出某种或多种真菌是司空见惯的。这就带来一个问题:如何判定一份来自所谓“开放”部位样本中培养出的真菌是否为病原菌。如从口咽或阴道分离出念珠菌,甲屑或皮屑中分离出霉菌,从皮损的表面培养出多种真菌,等等。
一般地,生物医学中将微生物能在宿主局部生长繁殖但不对宿主产生任何致病效应的状态称为共生(commensalism),但在宿主抵抗力下降时(如免疫受损或菌群失调)它们可转为致病状态,即在组织内增生造成组织破坏称为(机会性)感染(infection),如人类咽部或阴道内的念珠菌等;还有种微生物与宿主的相互关系叫寄居或定植(colonization),即菌株寄居在宿主某特定部位并与宿主局部组织密切接触。如上呼吸道中的曲霉或新生隐球菌。结局有三:①其数量达到损伤阈值触发宿主免疫应答病菌被清除,②两者相互作用造成组织损伤引起疾病,③病菌持续定植,造成慢性、潜伏携带状态,宿主免疫无法消除感染,如肺曲霉球、肺隐球菌感染等。还有一种情况就是菌种暂驻或偶落在人体开放部位被取材时带入培养基,继而长出菌落称之为污染。
这里要防止产生两种相反的错误认识。
一是将临床标本中培养出来的不属于常见致病真菌的气传真菌都看成是污染菌。实际上,随着临床对真菌感染问题的不断关注和对医学真菌学的日益重视,现在不断有以前认为是“污染菌”却引起真正的真菌感染的报道,但致病真菌身份的认定要靠组织病理和多次培养出同一菌种,必要时还需进行动物模型和原位杂交来证实;
二是将培养出来的真菌不加上述认定过程而一律当成致病菌看待甚至治疗.实际有可能只是共生状态甚或只是污染菌而已。如国内的许多流调报告,不密切结合临床表现,不进行菌株状态的认定,仅仅从真菌培养的结果汇总分析,就产生了我国或某地区或某医院某时段病原真菌的构成及变迁特征的报告,显得缺乏证据和严谨性,不能令人信服。
因此,当临床上从某一特定开放部位分离出真菌时,不管其是常见还是少见。对其意义的解释无论是致病还是污染一定要慎重。
优米app下载ios皮肤科致力于皮肤健康事业~~缔造健康肌肤,还您璀璨人生!
垂询热线:0516——83902308